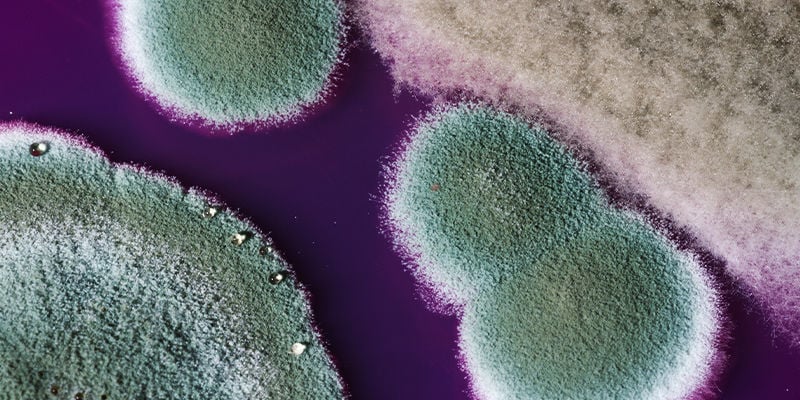

Con Quale Frequenza Andrebbe Cambiata L'Acqua Del Bong?
Se si usa per più sessioni di bonga, l'acqua può diventare rancida dopo poche boccate di fumo. Fidatevi di noi, è nel miglior interesse di tutti i partecipanti sostituirla con frequenza.
Vi è mai capitato di tirare una boccata da un bong e ritrovarvi con un orribile saporaccio stantio? Il fatto è che se l'acqua nella vostra pipa è stata lasciata a ristagnare, può completamente rovinare una fumata altrimenti perfetta. Potremmo dire che la pulizia è sacra. In quest'articolo parleremo della frequenza con cui dovreste cambiare l'acqua del bong per assicurarvi di gustare al massimo la vostra erba.
Perché si deve mettere l'acqua nel bong?

Perché si mette acqua nel bong? Cosa fa concretamente? In pratica, l'acqua funge da agente filtrante per il fumo della cannabis, eliminando certe sostanze e impedendo alla cenere di introdursi nella bocca e nei polmoni. Quando la cannabis brucia, si producono centinaia di composti secondari tossici e cancerogeni che penetrano nei polmoni con l'inalazione. Anche se l'acqua del bong non filtra tutti questi sottoprodotti tossici, nel complesso dà comunque un fumo più pulito. Inoltre, l'acqua raffredda il fumo prima che arrivi alla bocca, generando boccate più morbide che irritano meno i polmoni.
Quanto tempo si può lasciare l'acqua nel bong?
Non esiste risposta definitiva a questa domanda, dato che è possibile lasciare l'acqua nel bong per tutto il tempo che si vuole; in ultima istanza, dipende tutto dalle vostre preferenze personali e dalla vostra igiene! Tuttavia, cambiando l'acqua del bong dopo ogni fumata, manterrete pulita la vostra pipa e le vostre fumate saranno molto più gustose.
Vantaggi del cambiare spesso l'acqua del bong

Cambiare frequentemente l'acqua del bong comporta numerosi vantaggi, dal migliorare il gusto all'evitare agenti patogeni. Non farlo con regolarità sarebbe solo controproducente, sia per voi che per la vostra riserva d'erba. Ecco perché bisogna cambiare spesso l'acqua del bong.
Miglior sapore
Senza la presenza di acqua stagnante e stantia nel bong, potrete gustare tutte le sfumature e i raffinati aromi delle vostre varietà preferite. L'acqua fresca provvederà a rimuovere varie sostanze contaminanti senza nuocere al profilo gustativo dei vostri fiori.
Zero batteri
Lasciando acqua stagnante nel bong si crea il perfetto terreno di coltura per ogni sorta di batteri e può perfino portare alla crescita di muffa (cosa che bisogna assolutamente evitare!). Nessuno ha voglia di inalare fumo che è passato attraverso un'acqua infestata di batteri. Magari non vi ammalerete, ma è comunque disgustoso!
Allunga la vita del vetro
Prendersi cura del proprio bong lo farà durare più a lungo. Cambiando l'acqua regolarmente, terrete la vostra pipa protetta da macchie ed imperfezioni e, in generale, renderà molto più agevoli la pulizia e la manutenzione.
Miglior filtraggio
L'acqua pulita filtra molto meglio rispetto ad un'acqua che contiene cenere, materia vegetale e vari sottoprodotti tossici.
Il bong ha un aspetto migliore
Non soltanto il vetro si preserva più a lungo, ma avrà anche un aspetto migliore. Senza macchie o liquidi disgustosi, voi e i vostri compagni di fumate potrete apprezzare la bellezza della vostra pipa ad acqua ed il suo contenuto.
Come fare a sapere quando bisogna cambiare l'acqua del bong?

A parte prendere l'abitudine di cambiare l'acqua del bong dopo ogni fumata, ci sono alcuni segni rivelatori che indicano quando il liquido ha bisogno di una rinfrescata. Sebbene sia consigliabile cambiare l'acqua prima che appaiano questi segni, ecco alcuni degli indizi che indicano che il vecchio liquido va buttato e che bisogna ripartire con dell'acqua fresca.
Cattivo odore

Con tutti i batteri presenti nella vecchia acqua del bong, non c'è da meravigliarsi se comincia ad esalare un cattivo odore. Se trovate che il vostro bong puzza un po', è tempo per una bella ripulita e un cambio d'acqua.
Accumulo di resina
Alcune persone non esitano a raschiare la resina accumulata sulle pareti del bong e a fumarsela. Raccomandiamo però di non seguire tale pratica. Se notate degli accumuli di resina neri o marroni in qualunque parte del vostro bong, specialmente nella camera dell'acqua, dategli una bella pulita.
Muffa
Dato che l'acqua stagnante prima o poi genera muffa, è meglio agire rapidamente e dare alla vostra pipa una bella pulita in profondità prima di accenderla di nuovo. Batteri e muffe non dovrebbero mai crescere in un bong che viene usato regolarmente, e meno ancora nei polmoni e nella bocca di voi e dei vostri amici.
Acqua marrone
Questo è il segnale visivo più evidente. L'acqua marrone è assolutamente sgradevole alla vista e bisogna intervenire al più presto. Questa colorazione è data dalla resina e dal catrame presenti nel fumo di cannabis che, con il passare del tempo, macchiano il bong e favoriscono la crescita di agenti patogeni di ogni tipo.
L'acqua del bong può farvi venire la nausea?

Assolutamente sì! L'acqua sporca del bong ospita ogni sorta di batteri ed impurità, che non devono neanche essere lasciati avvicinare a bocca o polmoni. Perciò è meglio cambiarla spesso. E non fateci nemmeno parlare dell'idea di bere l'acqua del bong: sarebbe come mangiare il mozzicone di una sigaretta. Per nulla appetitoso, come certamente converrete.
Dritte per godere al massimo del bong
Abbiamo parlato delle ragioni per cui si dovrebbe cambiare regolarmente l'acqua del bong, ma non di come ottimizzare l'esperienza del fumare con il bong. Ecco alcuni suggerimenti per ottenere boccate filtrate da un apparecchio pulito.
Brilliant Bong Water

Questo pratico prodotto proposto dal team di Zamnesia è ideale per tenere il bong nelle migliori condizioni. Prima della prossima fumata, aggiungete un pochino di Brilliant Bong Water nel vostro attrezzo e non dovrete più preoccuparvi di depositi di resina o cenere! Una volta finito, semplicemente svuotatelo dal liquido e vi resterà un bong pulito e scintillante.
Filtro a carboni attivi
Con il vostro bong potete sempre usare un filtro a carboni attivi. Questo accessorio si inserisce fra il gambo ed il braciere e funge da strato di filtraggio aggiuntivo prima che il fumo raggiunga l'acqua. Perfetto per eliminare certi agenti contaminanti.
Pre-raffreddatore

Un pre-raffreddatore filtra il fumo attraverso uno scompartimento supplementare riempito d'acqua. Questo vuol dire che gran parte dei residui del fumo viene trattenuta nel pre-raffreddatore, impegnando meno la camera principale del bong.
Acqua distillata

Anche l'uso di acqua distillata è un'opzione valida per i bong. Quest'acqua pura contribuisce a ridurre i livelli di impurità e composti indesiderati nel bong, offrendo boccate più pulite e morbide.
Tenete pulito il vostro bong e non potete sbagliarvi
Come avrete capito a questo punto, tenere pulito il bong e cambiare regolarmente l'acqua è fondamentale per una fumata soddisfacente. Lasciare l'acqua a ristagnare crea soltanto più problemi che altro. Dedicando un po' di tempo a rinfrescare il vostro apparecchio, potrete godervi ogni volta fumate pulite e piacevoli!
-
7 min
12 febbraio 2024
Come Pulire Il Bong
Mantener limpio el bong puede parecer algo obvio, pero te sorprendería descubrir cuánta gente descuida sus pipas de agua. En este artículo dejamos las cosas claras y te enseñamos a mantener tu...
-
3 min
16 gennaio 2024
L'Acqua Del Bong Filtra Il THC?
Qualcuno potrebbe avere i sudori freddi pensando che l'erba può essere resa meno potente dalla capacità dell'acqua del bong di filtrare il THC. Continua a leggere per scoprire perché questa paura è...
-
6 min
11 novembre 2019
Vetro, Acrilico, Silicone O Ceramica: Scegliere Il Bong Giusto
Grandi, piccoli, a forma di drago—i bong sono disponibili in qualsiasi forma e dimensione. Possono essere variopinti, minimali o raffinati; possono costare solo pochi euro, o richiedere un esborso...
-
2 min
23 novembre 2015
Top 10 Bong e Pipe Fatti in Casa
Scoprire nuovi ed interessanti modi per fumare erba è sempre un divertimento: ecco a voi alcune idee fai-da-te tutte da sperimentare!
